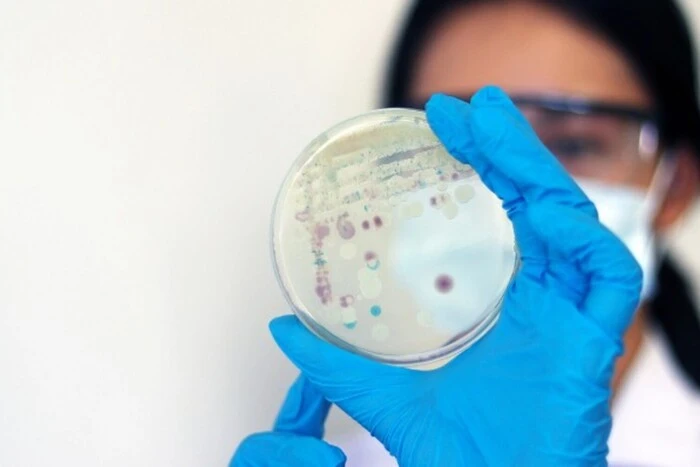

Житло втратили 160 тис. людей: Терехов заявив, що збитки Харкова від агресії РФ становлять близько €10,5 млрд
espreso.tv
Fri, 24 Oct 2025 17:54:00 +0300

Про це заявив мер Ігор Терехов, передає Укрінформ."Збитки по місту Харкову, тільки приблизно, 10,5 мільярдів євро складають. Це шалені кошти. Звісно, жодне місто, жодна громада, жодна держава не може самостійно це витримати. Ми потребуємо міжнародної підтримки", – сказав він.За словами Терехова, у Харкові пошкоджено або зруйновано 9 тис. будинків. Житло втратили 160 тис. містян, водночас його потребують і переселенці, яких наразі офіційно зареєстровано 207 тис."Вони ж не можуть усе своє життя жити у гуртожитках. Ми це розуміємо. Тобто потрібно, щоб ми уже зараз будували житло - і для вимушених переселенців, і для містян, які втратили житло. Нам потрібна комплексна відбудова", – зауважив міський голова.Водночас він акцентував: державної програми страхування від воєнних ризиків та пільгового кредитування потребує бізнес прифронтових міст та громад.Раніше Терехов заявив, що через знищення двох трансформаторних підстанцій ворогом прийдешня зима у місті може бути найскладнішою за весь час війни.